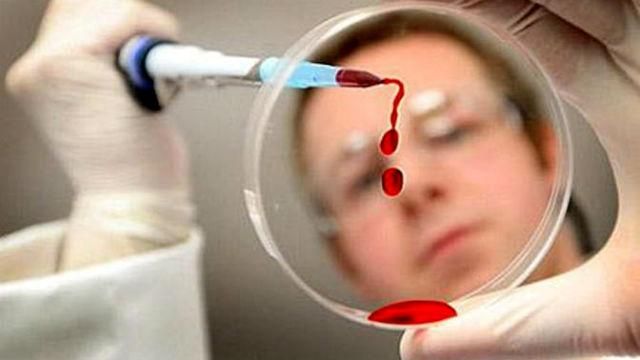
Китайские ученые научились создавать ГМО-людей Китайские ученые научились создавать ГМО-людей

Об этом сообщает научный журнал Nature.
Новый метод редактирования позволяет использовать ферменты, так называемые нуклеазы, чтобы отрезать определенный участок ДНК, а затем удалить или переписать генетическую информацию в этом месте.
В мире ученые уже опасаются, что из-за простоты этой методики в клиниках рождаемости начнут использовать ее без учета возможных последствий.
К слову, изменение половых генов людей запрещено в 29 странах мира, но в Америке, Китае и еще нескольких государствах изменение человеческих зародышей разрешено только при положительном решении правительства.
К слову, американская компания Rethink Robotics представила эмоционального промышленного робота. Новая модель под названием Sawyer весит всего 19 кг.